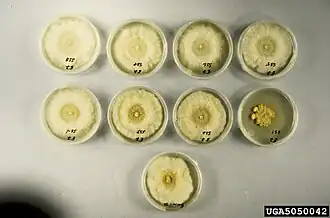

Kastanjekanker
| Kastanjekanker | |||||||||||||||
|---|---|---|---|---|---|---|---|---|---|---|---|---|---|---|---|
| |||||||||||||||
| Pycnidia van kastanjekanker op Amerikaanse kastanje | |||||||||||||||
| Taxonomische indeling | |||||||||||||||
| |||||||||||||||
| Soort | |||||||||||||||
| Cryphonectria parasiticas (Murr.) Barr (1978) | |||||||||||||||
| |||||||||||||||
| Jonge aantasting van kastanjekanker op Amerikaanse kastanje | |||||||||||||||
| Afbeeldingen op | |||||||||||||||
| Kastanjekanker op | |||||||||||||||
| |||||||||||||||
Kastanjekanker (Cryphonectria parasitica, synoniem: Endothia parasitica) is een schimmel in de orde Diaporthales van de ascomyceten, die op tamme kastanjes voorkomt. Kastanjekanker is in Nederland in Limburg, Noord-Brabant en Gelderland waargenomen.[1] Ook in België is de ziekte in 2015 gevonden. Aangetaste bomen worden direct vernietigd. Ook eiken (Quercus) kunnen geïnfecteerd worden, maar deze ondervinden hier weinig schade van. Het aantal chromosomen is n = 9.
Kastanjekanker is een quarantaineorganisme, waarvoor in bepaalde omstandigheden een meldingsplicht geldt en waarvoor beheersingsmaatregelen opgelegd kunnen worden (zie EU-verordening 2000/29/EC, blz. 54).[2]
De sporen infecteren de boom via kleine wondjes, scheurtjes in de bast en op plaatsen van afgebroken takken. In de bast en het cambium wordt een geel mycelium gevormd en ontstaat een oranje-bruine plek op de bast. Door het mycelium wordt het transport door het floëem geblokkeerd. Na infectie ontstaan een ingezonken plek of opgezwollen scheurtjes in de bast. Later verwelkt de boom boven de infectie- en ontstaan vochtige scheurtjes onder de infectieplaats. Ook verwelkte bladeren en in de winter nog droge bladeren aan de boom wijzen op een infectie.
In kleine, geel-oranje tot rode, 10-390 μm lange en 270-390 μm brede pycnidia, die op de bast gevormd worden, worden ongeslachtelijke pycnosporen (pycnidiosporen) op 12 - 23 μm lange conidioforen gevormd. Door de aan het uiteinde gelegen opening, de ostiole, worden de 1,5 × 2 μm grote, doorzichtige pycnosporen met de door het pycnidium gevormde, geel-oranje slijmmassa (cirrus of chirrus) naar buiten geperst. De draadvormige slijm met de sporen droogt daarna op en pas bij regen weken de sporen van het slijm los en worden dan verspreid (spatverspreiding). De slijmmassa bevat proteïnen en sachariden en beschermt voor ten minste 28 dagen de pycnosporen (pycnidiosporen) tegen uitdroging en voortijdige kieming.
Kastanjekanker is zowel zelfbevruchtend als kruisbevruchtend. Het vruchtlichaam is een perithecium met een lange nek, omdat het perithecium in het plantenweefsel ligt opgesloten. Ze liggen met 10 à 20 bij elkaar. Door de lange nek worden de tweecellige ascosporen bij droog weer uit de 40 tot 50 × 8 μm grote sporenzakjes weggeschoten en door de wind over grotere afstanden verspreid. De 10 × 4 μm grote ascosporen zijn doorzichtig en ingesnoerd bij de tussenwand. Uitstoting van ascosporen vindt hoofdzakelijk plaats in de eerste vijf uur na regen en bij een temperatuur van 20 - 27 °C.
Verspreiding
Kastanjekanker komt van nature voor in Oost-Azië en veroorzaakt daar weinig schade aan kastanjebomen.
In 1904 kwam de Oost-Aziatische schimmel mee met bomenmateriaal van Castanea crenata van een Japanse kwekerij naar Noord-Amerika.[3] De schimmel werd voor het eerst gevonden in New York in de New York Zoological Garden (the "Bronx Zoo") door Herman W. Merkel, een boswachter van de Zoo. In 1905 isoleerde de Amerikaanse mycoloog William Murrill de schimmel en beschreef deze als Diaporthe parasitica. Hij paste vervolgens de postulaten van Koch toe en inoculeerde gezonde bomen met het isolaat om te zien of het de voor de symptomen verantwoordelijke schimmel was.[4] Rond 1940 waren de meeste Amerikaanse kastanjebomen (Castanea dentata) afgestorven.[5] In Europa werd de schimmel voor het eerst in 1938 ontdekt in het achterland van het Italiaanse Genua. Vandaar uit verspreidde de ziekte zich snel in het Middellandse Zeegebied. In de jaren 1940 kwam de schimmel ook voor in Spanje en Zwitserland, in de jaren 1950 verder in Frankrijk, Kroatië, Slovenië, in de jaren 1960 in Albanië, Bosnië en Herzegovina, Griekenland, Hongarije, Oostenrijk en Turkije, in de jaren 1970 in Macedonië, Groot-Brittannië en Slowakije.[6] Daarna ook in Roemenië (1984), Portugal (1989) en Duitsland (1992).[6]
Hypovirulentie
Veel stammen van kastanjekanker veroorzaken slechts oppervlakkige kankerplekken, die bij de tamme kastanje snel weer helen. Dit wordt hypovirulentie genoemd. Op een voedingsbodem vormen deze stammen geen of weinig pycnidiën en is het mycelium wit in plaats van geel. Deze stammen blijken besmet te zijn met het dubbelstrengige RNA (dsRNA) Cryphonectria hypovirus 1 (CHV1), dat tot het geslacht Hypovirus behoort. Het virus wordt overgedragen tussen dezelfde vegetatieve compatibiliteitstypen (vc-typen). De overdracht vindt plaats door anastomose (samengroeien) van de schimmeldraden. Het virus komt ook in 20 tot 90% van de ascosporen voor. In Europa komen in totaal ongeveer 64 compatibiliteitstypen voor, waarvan in Frankrijk meer dan 40 voorkomen, in Italië, Bosnië en Zwitserland 20 tot 30 en in Oostenrijk 15. In Griekenland, waar alle kastanjeboomopstanden aangetast zijn, komen er maar 4 voor.[6] In de Verenigde Staten komen veel meer compatibiliteitstypen voor dan in Europa.
Vegetatieve compatibiliteit berust op vijf tot zeven loci. Alleen wanneer twee stammen op alle loci dezelfde allelen hebben, groeien hun schimmeldraden door anastomose aan elkaar.[7]
Biologische bestrijding
Kastanjekanker wordt in Europa biologisch bestreden door geïnfecteerde bomen met een hypovirulente stam te injecteren. Dit wordt vooral toegepast in Frankrijk, Hongarije, Griekenland, Slowakije en Zwitserland.[6]
Externe links
- ↑ Menno Boomsluiter. (2013) Aandacht voor exotische paddenstoelen in Nederland
- ↑ EU-verordening 2000/29/EC. Gearchiveerd op 13 maart 2022.
- ↑ http://www.columbia.edu/itc/cerc/danoff-burg/invasion_bio/inv_spp_summ/Cryphonectria_parasitica.htm. Gearchiveerd op 21 oktober 2022.
- ↑ Rogerson CT, Samuels GJ (1996). Mycology at the New York Botanical Garden, 1985-1995. Brittonia 48 (3): 389–98. DOI: 10.1007/bf02805308.
- ↑ Susan Freinkel, American Chestnut: The Life, Death, and Rebirth of a Perfect Tree, p 81
- ↑ a b c d C. Robin, U. Heininger: Chestnut blight in Europe: Diversity of Chryphonectria parasitica, hypvirulence and biocontrol. Forest, Snow and Landscape Research, Band 76, 2001, S. 361–367.
- ↑ [Anagnostakis, S.L 1982. Genetic analyses of Endothia parasitica: linkage data for four single genes and three vegetative compatibility types. Genetics 102: 25-28.]

.jpg)